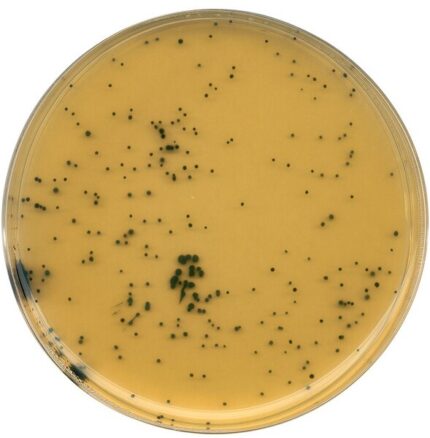
محیط کشت تریپتوز سولفیت سیکلو سرین , کد مرک 111972 , Tryptose Sulfite Cycloserine Agar

محیط کشت MRS Agar کد مرک ۱۱۰۶۶۰
جهت خرید محیط کشت MRS Agar کد مرک 110660 اصل و با کیفیتی تضمینی، برند مرک از آرمان کیمیا زیست، تامین کننده مواد شیمیایی آزمایشگاهی با بیش از ۳۰ سال سابقه
محیط کشت MRS Agar کد مرک ۱۱۰۶۶۰: انتخاب برتر برای کشت و جداسازی لاکتوباسیل ها
محیط کشت MRS Agar (de Man, Rogosa and Sharpe) با کد مرک ۱۱۰۶۶۰ یک محیط کشت انتخابی است که به طور ویژه برای کشت، شمارش، جداسازی و شناسایی باکتریهای لاکتوباسیلوس و سایر باکتریهای اسید لاکتیک طراحی شده است. این محیط کشت با فراهم کردن شرایط تغذیهای ایدهآل، رشد بهینه لاکتوباسیلها را تضمین کرده و در عین حال از رشد سایر باکتریها جلوگیری میکند.
ویژگیهای فیزیکوشیمیایی:
- شکل ظاهری: پودر به رنگ بژ روشن
- حلالیت: به راحتی در آب مقطر حل میشود (۶۶.۲۴ گرم در لیتر)
- pH: محلول ۱.۶۶% در دمای ۲۵ درجه سانتیگراد دارای pH بین ۵.۵ تا ۵.۹ است.
کاربردها:
- صنایع غذایی: MRS Agar به طور گسترده در صنایع غذایی برای کنترل کیفیت محصولات لبنی، نوشیدنیها، گوشت و سایر مواد غذایی تخمیری استفاده میشود. این محیط کشت امکان شناسایی و شمارش دقیق لاکتوباسیلها را فراهم میکند که نقش حیاتی در فرآیند تخمیر و حفظ کیفیت محصولات دارند.
- تحقیقات میکروبیولوژی: این محیط کشت یک ابزار ضروری در تحقیقات میکروبیولوژی برای جداسازی، شناسایی و مطالعه باکتریهای اسید لاکتیک است.
- صنایع دارویی و پروبیوتیک: در تولید پروبیوتیکها و مکملهای غذایی حاوی لاکتوباسیلها، MRS Agar برای کنترل کیفیت و تضمین خلوص محصولات استفاده میشود.
دستورالعمل استفاده:
- آمادهسازی محیط کشت: 66.۲۴ گرم از پودر را در یک لیتر آب مقطر حل کنید.
- استریلیزاسیون: محلول را به مدت ۱۵ دقیقه در دمای ۱۲۱ درجه سانتیگراد اتوکلاو کنید.
- ریختن در پلیت: محیط کشت استریل شده را در پلیتهای استریل بریزید و بگذارید تا سفت شود.
- کشت نمونه: نمونه مورد نظر را بر روی سطح محیط کشت کشت دهید.
- انکوباسیون: پلیتها را به مدت ۴۸ تا ۷۲ ساعت در دمای ۳۰ تا ۳۷ درجه سانتیگراد در شرایط بیهوازی یا کمهوا انکوبه کنید.
- بررسی نتایج: پس از انکوباسیون، کلنیهای لاکتوباسیلها را بر اساس مورفولوژی و سایر ویژگیها شناسایی و شمارش کنید.
حجمها و بستهبندی:
- بستهبندی ۵۰۰ گرمی: مناسب برای آزمایشگاههای با حجم کاری بالا
- بستهبندیهای کوچکتر: برای آزمایشگاههای با حجم کاری کمتر نیز موجود است.
مزایای استفاده از MRS Agar کد مرک ۱۱۰۶۶۰:
- انتخابی بودن بالا: این محیط کشت به طور خاص برای رشد لاکتوباسیلها طراحی شده و از رشد سایر باکتریها جلوگیری میکند.
- حساسیت بالا: امکان شناسایی و شمارش حتی تعداد کمی از لاکتوباسیلها را فراهم میکند.
- سهولت استفاده: دستورالعمل استفاده ساده و قابل فهم است.
- کیفیت تضمین شده: محصول شرکت مرک با استانداردهای کیفی بالا تولید میشود.
نتیجهگیری:
محیط کشت MRS Agar کد مرک ۱۱۰۶۶۰ یک ابزار قدرتمند و قابل اعتماد برای کشت، جداسازی و شناسایی باکتریهای لاکتوباسیلوس است. این محیط کشت با ویژگیهای منحصر به فرد خود، انتخابی بودن بالا، حساسیت بالا و سهولت استفاده، به عنوان یک ابزار ضروری در صنایع غذایی، تحقیقات میکروبیولوژی و صنایع دارویی شناخته میشود. با استفاده از این محیط کشت، میتوانید با اطمینان کامل به کنترل کیفیت محصولات خود بپردازید و تحقیقات خود را با دقت و کارایی بالا انجام دهید.

دیدگاهها
هیچ دیدگاهی برای این محصول نوشته نشده است.